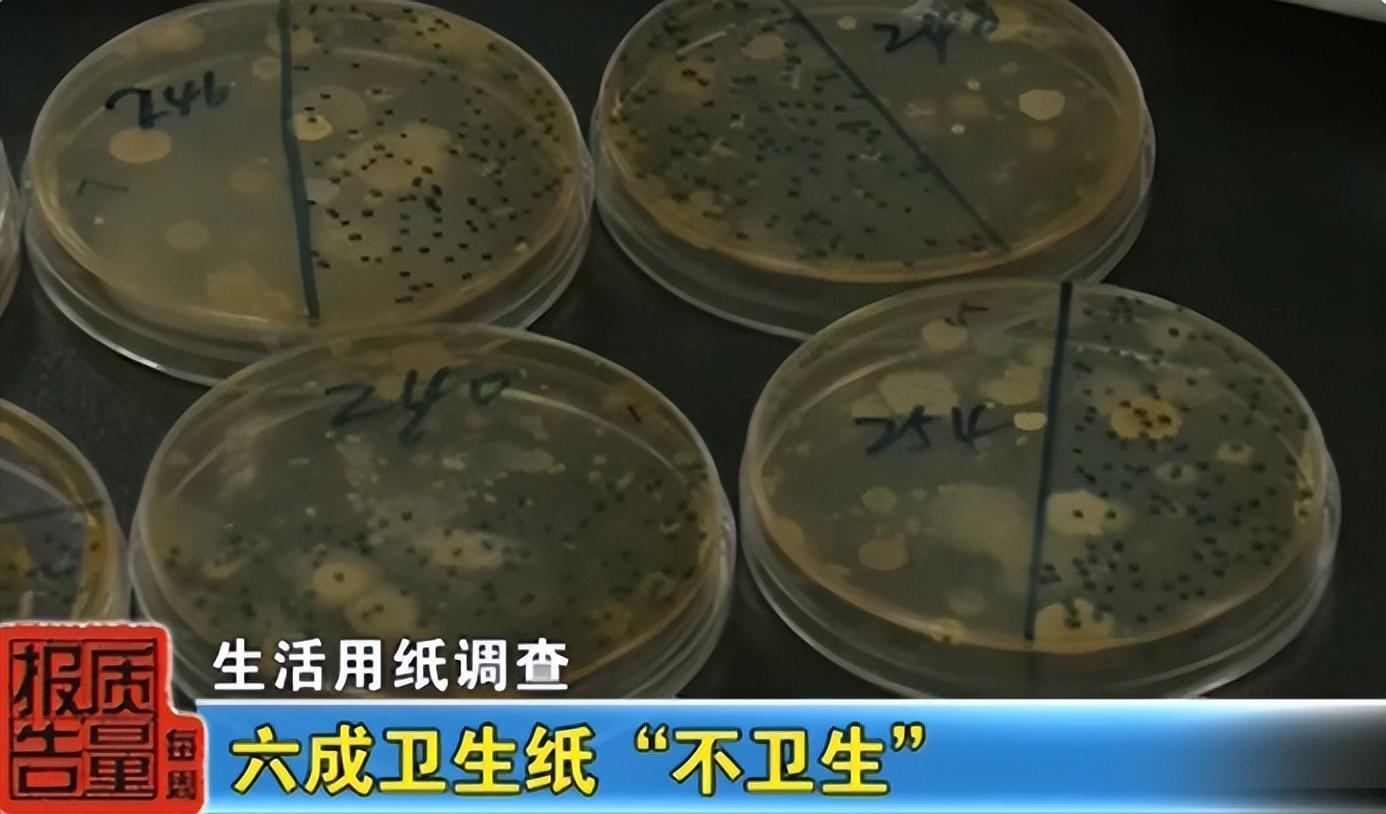

央視曝光“毒紙巾”,有毒還致癌?提醒:少了這幾個字,建議別買
最近,一個奇怪的話題引起廣大網友的關注,甚至衝上了網絡熱搜:
免費的紙巾不能用!
原來,有不少網友有過相同經歷:平時在馬路上、超市門口、商店附近被陌生人硬塞一堆免費紙巾。
有人用完紙巾後,身體出現不適。杭州女孩小蘭就曾因使用這種紙巾擦嘴,長出疹子。醫生告訴她,這類紙巾比較劣質,可能存在嚴重細菌超標問題,可能誘發細菌感染引起婦科疾病,如尿道炎、陰道炎、盆腔炎等。
小蘭連忙表示自己再也不貪小便宜,醫生卻說:“毒紙巾”並非只出現在“免費發放”裏,生活中的“毒紙巾”,其實比比皆是。

一、央視曝光“毒紙巾”,不僅有毒,甚至致癌
2019年,央視欄目——《每週質量報告》對隨機抽選了一批生活用紙進行檢測。令人震驚的是,我們以爲安全的紙巾,竟然存在巨大隱患。
這次共抽取了150批次紙巾樣品,發現有35批次樣品不合格,不合格率高達24%。更有甚者,有19批樣品紙巾偷工減料,9批次樣品紙巾細菌菌落總數嚴重超標,超出國標13倍,具有致癌風險。
一些不良商家會用回收來的處理不完全的生活垃圾,比如廢紙、碎布、爛紗布等爲原料,通過違規添加大量的熒光增白劑、工業滑石粉等,讓紙張更白更柔軟,賣相更好。

還有另一種毒紙巾,同樣令人擔憂:
根據《衛報》的消息,全國範圍內多地的紙巾都被檢查出含有全氟烷基和多氟烷基物質這項有毒物質。這種物質是對人體有害的“永久性化學品”,跟癌症、肝臟疾病、胎兒併發症、自身免疫性疾病、腎臟疾病和其他嚴重的健康問題有關。

二、“毒紙巾”防不勝防,3招教你鑑別
不合格紙巾使用場景其實非常多,路邊小店、公共廁所等,而誤用了“不合格紙巾”,可能會導致以下健康問題:
皮膚過敏:細菌超標的紙巾會對皮膚產生直接的損害,有可能會導致皮膚過敏起紅疹子。
導致泌尿科/婦科疾病:如果上廁所用了問題紙巾,問題紙巾直接接觸私處,有可能引發私處感染,誘發婦科病或者泌尿科疾病。
導致腸道疾病:如果問題紙巾中含有大腸桿菌、幽門螺旋桿菌等細菌,很可能會導致人體的腸炎、肝炎等病。
損害神經系統、血液系統:如果問題紙巾含有過量的熒光增白劑、滑石粉、漂白劑等物質,很可能會引發白血病、損害神經和血液系統,還可能致使小朋友智力低下和發育遲緩。

如果不確定正在使用的紙巾是否不合格,可以使用以下三種方法鑑別:
泡水法:將紙巾放入水中,如果紙巾變成一灘碎末,切勿使用。
撕開法:用手將紙巾撕開,如果紙巾一扯就裂開,毫無韌勁,且會掉灰塵,切勿使用。
燃燒法:用火燃燒紙巾,如果紙巾最後變成一堆白色的灰,或者有黃色殘留物,切勿使用。
如何在購買時就避開“毒紙巾”?可以參考以下三個標準:
- 看準執行標準
紙巾通常分爲衛生紙(捲紙)與紙巾紙(抽紙、手帕紙等)兩類。衛生紙的執行標準是GB20810,要求細菌菌落總數低於600cfu/g,紙巾紙的執行標準是GB20808,要求細菌菌落總數低於200cfu/g,符合該標準的就能夠放心使用。但注意衛生紙與紙巾紙的標準不一樣,生活中不建議使用捲紙來擦嘴擦臉。

- 看質量等級
紙巾的質量等級有優等品、一等品以及合格品,質量等級越高越好,優等品與一等品爲上上選。
- 看原料
紙巾的原料一般有原生木漿、純紙漿以及原生漿幾種,原生木漿指的是純天然木材製作的紙漿,製作出來的紙巾柔軟度高,品質好;原生漿指天然植物漿,製作出來的紙巾品質較好;純木漿指純木材紙漿,有可能是回收的廢紙製作的,品質較差。
三、日常使用紙巾,牢記“三不要”
即使是合格紙巾,如果使用方法不恰當,也會對身體健康產生不利的影響。
1、不要用紙巾包食物
紙巾看似雪白乾淨,但通常沒有滅菌工序,很可能含有大量的細菌,尤其是紙巾開封暴露在空氣中,很可能附着各種細菌。此外,廚房用紙也不建議用來包食物,包食物建議使用烘焙紙。

2、不要盲目使用溼廁紙
有的溼廁紙中含有殺菌成分,如果選擇合格品,在產品安全方面無需擔心。但溼廁紙中的殺菌成分可能會引起一部分皮膚敏感的人過敏,還有可能破壞女性的陰道菌羣平衡。
3、不要使用公廁紙巾
公廁中的紙巾可能經過很多人的觸碰,有可能掉地上粘上細菌與灰塵,所以,建議外出上廁所自帶紙巾,對自己的健康更有保障。

參考資料:
[1]《“毒紙巾”遭曝光,可能致病又致癌!提醒:不符合這個標準的千萬別買!》.我是大醫生官微. 2024-01-30
[2]《千萬別用!央視曝光:這種紙巾,比抹布還髒,還有致癌風險……》.安全健康教育 .2023-09-08
[3]《全球多地衛生紙中檢出永久有毒化學品》.大河報. 2023-03-16

















